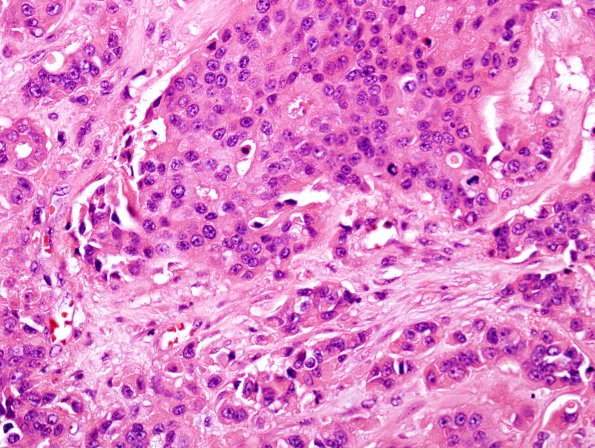
94A Metastases, Breast (Case 94) H&E 1

Table of Contents
Washington University Experience | NEOPLASMS (METASTASES) | Microscopic | 94A Metastases, Breast (Case 94) H&E 1
Case 94 History ---- The patient is a 55 year old woman with a history of breast cancer and now with an enhancing right cerebellar mass. Clinical diagnosis: Metastasis vs meningioma. This is a metastatic carcinoma composed of nodules, nests, and cords of pleomorphic malignant cells with increased nuclear:cytoplasmic ratio, prominent nucleoli, and eosinophilic cytoplasm. In some areas the cells appear to be forming glands. Multiple areas of necrosis are also present. The tumor has high mitotic activity and a relatively sharp distinct demarcation with the adjacent uninvolved cerebellum. ---- 94A Lobules and infiltrating individual tumor cells accompany a stromal reaction. (H&E)